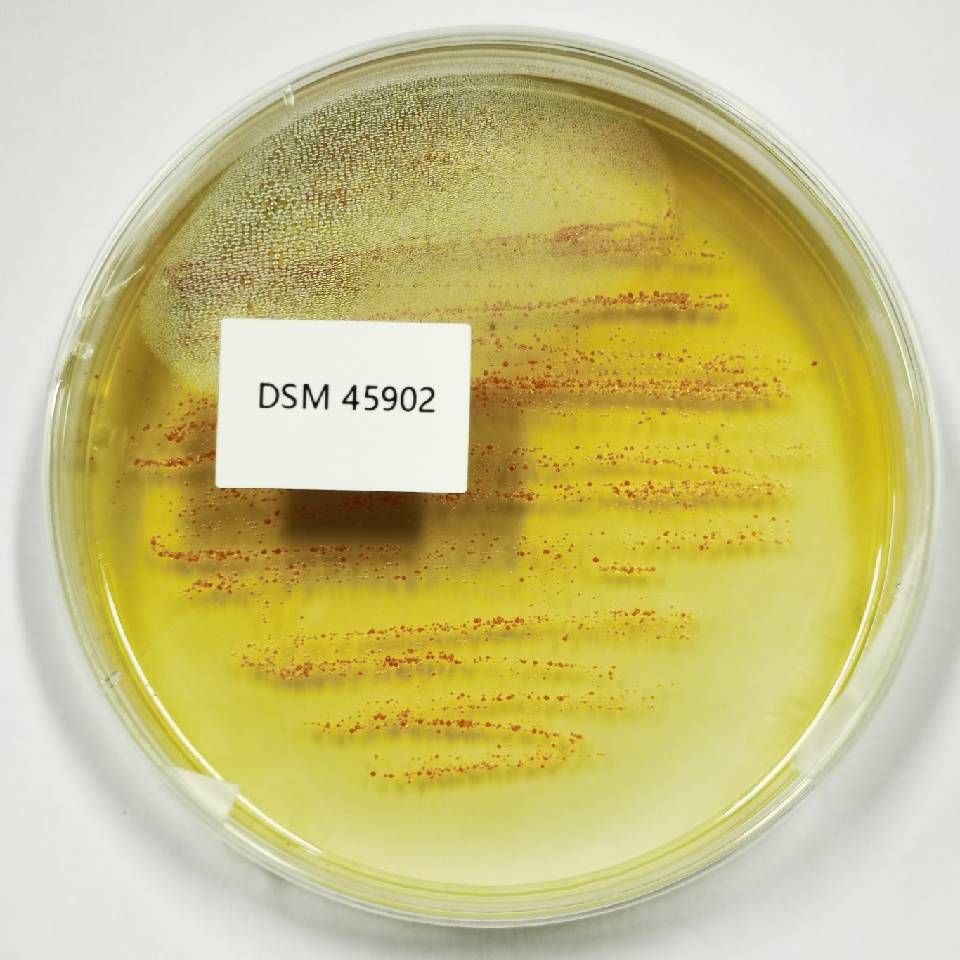
菌株

菌株
atcc
询价
1株
起订
浙江 更新日期:2025-07-09
产品详情:
- 中文名称:
- 菌株
- 英文名称:
- atcc
- 保存条件:
- 2-8
- 产品类别:
- 菌株
公司简介
宁波泰斯拓生物技术有限责任公司与浙江明哲生物技术有限公司合作,建有现代化的微生物实验室,配备先进的实验仪器,具向社会各界提供古菌、细菌、放线菌、酵母菌、丝状真菌等共享菌种资源,包括模式菌株、标准菌株(质控菌株)、生产菌株、以及用于研发的菌株,覆盖了科研、教育、农林、工业、海洋等行业的科研、生产和检验用菌种。
? ?公司成立以来,经过不懈的努力与发展,已具有一定的规模与实力。公司生产销售的产品品种多样、质量可靠,覆盖科研领域,长期助力国内外各大高校、研究机构、工厂、企业科研,目前拥有一家整体十万级局部百级的GMP生产车间及设备完善的生物学实验室,已建立一套严格的实验技术操作规范和质量控制体系。公司人员90%为本科及以上学历,生物科研实力雄厚,旨在为全球企业和生命科学研究机构提供高质量的生物试剂产品和高水平的技术服务。
企业文化:
自由 平等 创新 分享 进取
经营理念:
专业 品质 服务 效率 价值
| 成立日期 | (6年) |
| 注册资本 | 100 |
| 员工人数 | 10-50人 |
| 年营业额 | ¥ 500万-1000万 |
| 经营模式 | 工厂 |
| 主营行业 | 通用试剂 |
菌株相关厂家报价
-

- ATCC ATCC代购 ATCC细胞 ATCC官网 原代ATCC细胞
- 吉奥蓝图(广东)生命科学技术中心 VIP
- 2026-04-09
- ¥9999
-

- ATCC 1640培养基
- 维百奥(北京)生物科技有限公司 VIP
- 2026-03-02
- 询价
-

- ATCC菌株
- 广州弗尔博生物科技有限公司
- 2026-01-07
- 询价
-

- ATCC细胞/ATCC菌株/ATCC菌种--原厂采购/购买/ATCC代理,原管原装,非传代
- 上海可芃生物科技有限公司
- 2025-12-23
- 询价
-

- ATCC
- 青旗(上海)生物技术发展有限公司 VIP
- 2025-09-09
- ¥100
-

- 铜绿假单胞菌-化妆品检测-大肠埃希氏菌
- 上海川翔生物科技有限公司
- 2012-02-24
- 询价
-

- ATCC标准品
- 广州弗尔博生物科技有限公司
- 2026-01-07
- 询价